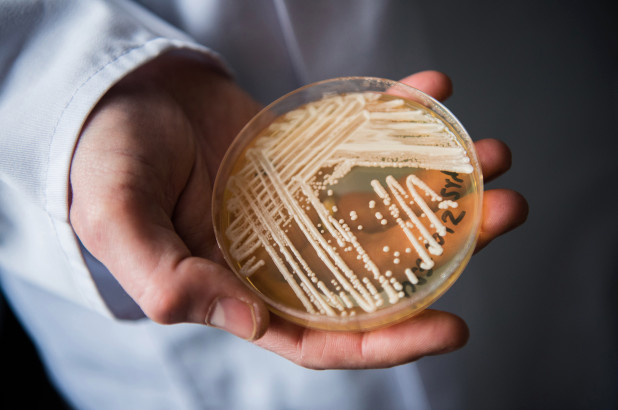

這對人類來說絕對是一大警訊啊!因為濫用抗生素的關係,這讓人體開始出現了抗藥性,而這種狀況造成的影響就是當你被感.染的話,藥物可能就會沒有治療的效果,讓你只能在細.菌或病.毒的侵.襲下沒了生命,更可怕的是,近幾年就真的有這種「超級黴.菌」正在全球擴散當中,甚至連台灣也曾出現過一起案例。
在去年5月的時候,美國紐約出現了一名病患在西奈山醫院進行了一項手.術,結果在驗血時卻發現他感染了超級黴菌「耳念珠菌」 (Candida auris) ,雖然之後趕緊將這名病患進行隔離,但是卻沒有藥物可以有效治療,因此病患在90天後還是沒了呼吸心跳。更駭人的是,這名病患把耳念珠菌給留了下來,他待過的病房全都被黴菌感.染,不只是病床,甚至連窗簾、電話、牆壁到房門都是如此,只要用特別的消毒工具才有辦法清除這黴.菌,據悉為了阻止黴.菌從病房擴散出去,醫院還將部分的天花板給拆了銷毀。

其實耳念珠菌在2009年就已經出現,首次發現是在日本,沒想到近年來不管是美洲、歐洲、印度或是非洲都出現了耳念珠菌的案例,讓科學家非常驚訝這樣的擴散速度。而這種超級黴.菌的感.染高風險群主要是嬰兒、老年人和糖尿病患等免疫機能不成熟或受.損的人群,只要一感染,死.亡率就達30%至90%,大多人都是在90天內喪.命,因此美國疾病防治中心 (CDC) 已經將耳念珠菌列為「緊急威脅」的黴菌名單,希望大家可以多注意。

目前美國已經出現587起案例,多數出現在新澤西州、伊利諾州和紐約,台灣在去年4月時也有出現過,但因為是較輕的症狀,所以接受治療後也順利康復,並在緊急控制後也沒有造成擴散。至於有關耳念珠菌,它有90%對1種抗生素有抗藥性,30%對2種或多種的抗生素有抗藥性,因此非常難根治或根除,就有英國研究顯示,如果不想辦法減緩耳念珠菌等超級黴菌的出現的話,全世界在2050年時至少會有1000萬人因為感.染而失去性命,另外有800萬人也會死於.癌.症。
TEEPR吃不胖編:只有3個月可以活,也太可怕!

(往下還有更多精彩文章!)